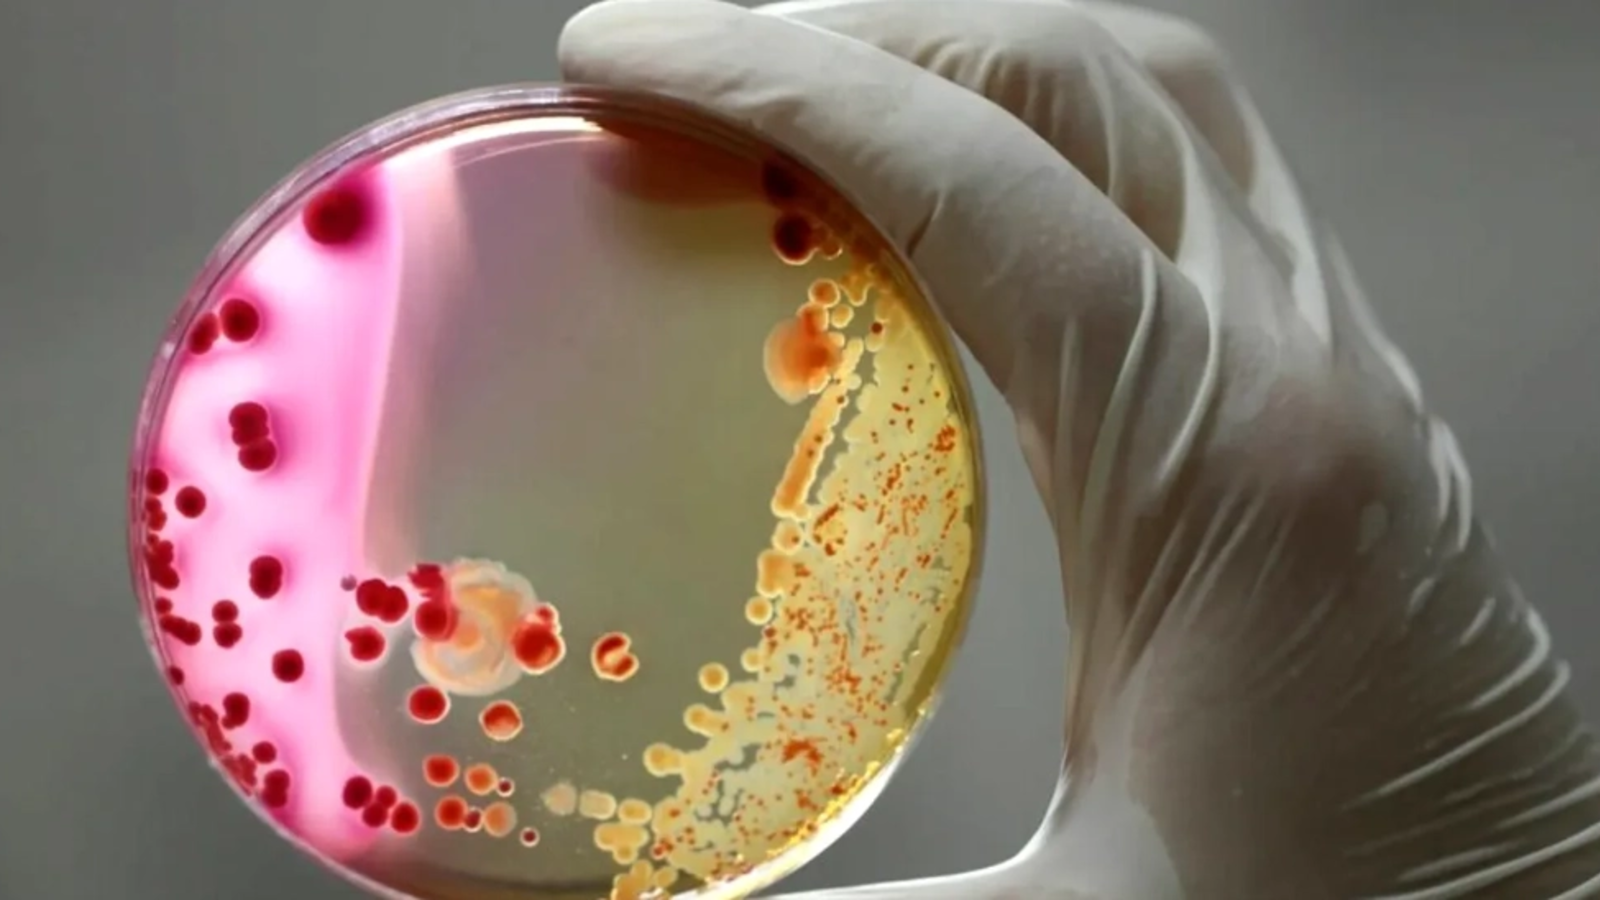

Amigdalita streptococică este o boală frecventă a copilăriei, dar la câțiva copii această infecție bacteriană poate duce la schimbări alarmante și de durată în comportament. Oamenii de știință abia încep să dezlege modul în care ea afectează creierul, scrie BBC, informează Mediafax.
În ziua în care Charlie Drury a împlinit opt ani, viața lui s-a schimbat pentru totdeauna.
Era noiembrie 2012, iar ziua avea toate ingredientele obișnuite pentru o aniversare – tort, cadouri și mâncare tematică de petrecere.
Comportament neobișnuit
Dar, pe măsură ce orele treceau, mama lui Charlie, Kate Drury, a observat ceva ciudat în comportamentul fiului său.
Totul a început cu un clipit neobișnuit al ochilor, apoi băiatul și-a tot mirosit mâinile. Mai târziu, în aceeași zi, a făcut febră.
Drury l-a dus la o clinică de urgențe aproape de casa familiei din Illinois, SUA, unde a fost diagnosticat cu faringită streptococică.
În săptămânile care au urmat, sănătatea lui Charlie s-a deteriorat în moduri care au derutat-o complet pe Drury.
A devenit atât de sensibil la mirosuri, încât mama sa a fost nevoită să nu mai gătească în casă.
A dezvoltat o anxietate extremă de separare, dar în același timp, atingerile mamei îl făceau să țipe și să se frece cu furie în locul unde pielea lor se întâlnise.
Dormea foarte puțin, a devenit anorexic și a refuzat să se mai spele.
Arunca obiecte prin casă. Avea halucinații. Se chinuia să citească și să scrie.
Drury abia își mai recunoștea fiul, care până atunci fusese un elev și un sportiv promițător, fără probleme de comportament.
„Mi-am pierdut copilul într-o singură zi”, spune Drury.
Pandas, o afecțiune puțin cunoscută, din fericire, extrem de rară
După mai bine de o lună de chin și confuzie, medicii l-au diagnosticat pe Charlie cu o afecțiune puțin cunoscută, numită „tulburări neuropsihiatrice autoimune pediatrice asociate cu infecțiile streptococice”, sau Pandas.
Copiii cu Pandas trec printr-un debut brusc și accentuat al unor ticuri și/sau simptome de tulburare obsesiv-compulsivă, care apar adesea peste noapte.
Tot atât de brusc, un copil cu Pandas poate dezvolta o listă lungă de alte probleme, precum regresii în dezvoltare sau în abilități motorii, comportament agresiv și imprevizibil, schimbări bruște de dispoziție, dureri, iritabilitate și tulburări de somn, printre altele.
Prevalența exactă a afecțiunii este greu de stabilit, dar experții sunt de acord că Pandas nu este comună.
O estimare arată că unul din 11.800 de copii ar putea dezvolta Pandas sau o afecțiune înrudită, numită sindrom neuropsihiatric pediatric cu debut acut (Pans), într-un an – deși cifrele variază dramatic de la un studiu la altul.
Totuși, datele dintr-un registru internațional de pacienți sugerează că tulburarea apare mai des la băieți decât la fete și lovește copiii înainte de pubertate.
„Simt că nu mai e copilul meu. Parcă e posedat”
„Din motive evidente, părinții sunt complet îngroziți” atunci când aceste simptome apar, spune Shannon Delaney, neuropsihiatru de copii și adolescenți care tratează pacienți cu această afecțiune la New York, SUA.
„Aud frecvent părinți spunând: «Simt că nu mai e copilul meu acolo. Parcă ar fi posedat».”
Cercetătorii de la National Institutes of Health din SUA au descris pentru prima dată Pandas în anii 1990.
Încă de atunci, ideea că infecțiile streptococice ar putea provoca complicații neurologice nu era nouă. În 1894, medicii descriseseră pacienți cu o afecțiune neurologică numită coreea Sydenham, dezvoltată după infecții în gât.
Aproximativ 100 de ani mai târziu, un grup condus de Susan Swedo, pe atunci șefa secției de pediatrie și neuroștiințe de dezvoltare de la NIH, a publicat dovezi care sugerau că infecțiile streptococice erau legate și de apariția bruscă și șocantă a unor simptome neuropsihiatrice tipice pentru pacienții cu Pandas.
Ghinionul de a avea un sistem imunitar cu o anumită predispoziție genetică
„Streptococul nepotrivit, la un copil ghinionist… duce la un răspuns imun eronat” – Susan Swedo
Cum ar putea o simplă angină streptococică – o boală banală, contractată anual de sute de milioane de copii din întreaga lume – să provoace un răspuns atât de intens la un mic procent dintre ei?
Aceasta a fost tema unei dezbateri științifice aprinse în anii care au urmat.
Dar Swedo, care este în prezent director științific la Pandas Physicians Network din SUA, rezumă astfel situația: „Streptococul nepotrivit, la un copil ghinionist… duce la un răspuns imun eronat.”
Cu alte cuvinte, sistemul imunitar al unor copii – probabil cei cu o predispoziție genetică – reacționează greșit atunci când încearcă să lupte împotriva unei infecții streptococice, producând anticorpi care atacă propriile țesuturi sănătoase.
Acești anticorpi par să pătrundă în creier și să provoace haos. Studiile pe animale sugerează că acest lucru s-ar putea întâmpla deoarece unele celule imunitare generate ca răspuns la infecția streptococică călătoresc de-a lungul nervilor care merg de la nas la creier și slăbesc bariera de protecție a creierului.
Unii oameni de știință continuă să pună sub semnul întrebării această ipoteză
Totuși, mai multe echipe de cercetare au publicat studii care arată existența inflamației și a altor modificări în creierele copiilor cu Pandas – în special la nivelul ganglionilor bazali, care joacă un rol în controlul motor, învățare, luarea deciziilor și răspunsurile emoționale.
Tulburarea obsesiv-compulsivă (TOC) a fost și ea asociată cu disfuncții în ganglionii bazali.
Jennifer Frankovich, reumatolog pediatru și director al Stanford Immune-Behavioral Health Program din SUA, a cărei echipă a realizat cercetări legate de inflamația cerebrală asociată Pandas, afirmă că aceste descoperiri sunt importante deoarece indică faptul că „este o tulburare reală”, cauzată de un răspuns autoimun, și nu o simplă problemă psihologică.
Pentru părinții care se confruntă cu schimbări dramatice și bruște în comportamentul copiilor lor, această constatare în sine poate fi de mare valoare, mai ales întrucât există tendința de a pune totul pe seama unei educații greșite, explică Frankovich.
Și alte boli respiratorii obișnuite, inclusiv gripa, au fost asociate cu simptome asemănătoare Pandas
Cercetări preliminare sugerează, de asemenea, că Sars-CoV-2, virusul care provoacă Covid-19, poate agrava simptome existente sau genera unele noi – poate prin intensificarea inflamației în organism și/sau prin reactivarea unor viruși latenți, după cum a teoretizat un studiu din 2023. Cercetările și experiența clinică ale lui Delaney sugerează că și infecțiile transmise prin mușcături de căpușe, care provoacă boala Lyme, pot fi un factor declanșator al simptomelor.
Când un agent patogen altul decât streptococul pare să declanșeze simptome neuropsihiatrice cu debut brusc – sau când medicii nu pot identifica un factor clar – copiii primesc diagnosticul mai general de Pans.
Deși există și alte diferențe în criteriile de diagnostic, Pandas este considerată o subcategorie a Pans.
Infecțiile pot deveni devastatoare pentru pacienții cu Pans/Pandas timp de mulți ani, spune Sarah O’Dor, psiholog clinician și director al Pediatric Neuropsychiatry and Immunology Program de la Massachusetts General Hospital din Boston.
Perioade de remisie alternate cu perioade de recidivă
Simptomele Pans/Pandas fluctuează, cu perioade de remisie aproape totală ce pot dura ani întregi. Dar apoi, „dacă copilul se îmbolnăvește din nou – fie de streptococ, fie de Covid – simptomele revin brusc”, spune O’Dor.
Găsirea tratamentelor pentru aceste simptome, fie la debut, fie în fazele de recidivă, poate fi o adevărată odisee pentru pacienți și familiile lor.
Puțini clinicieni sunt specializați în Pans/Pandas, iar unii refuză să trateze afecțiunea sau chiar îi contestă existența.

Comentează